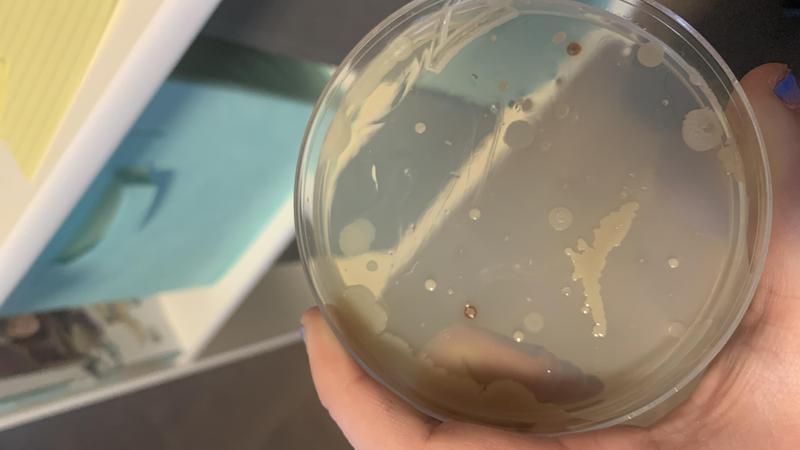

Grade 7 student’s love for science takes her to national fair
Kaitlyn Rumohr is just 13-years-old, but she’s already blazing a trail toward a career in medicine.
Rumohr, a grade seven student at Glendale School in Red Deer, recently participated in the Canada-Wide Science Fair hosted by Youth Science Canada.
The event was virtual of course, for a second straight year, but Rumohr, who received a gold medal at the regional level to qualify, says it was still a great experience.
“I’ve always had an interest in science, mostly in biology and how the human body works, and I’ve always wanted to be a surgeon,” she says. “I really find in interesting learning about how medications work to kill bacteria, and how the immune system works.”



